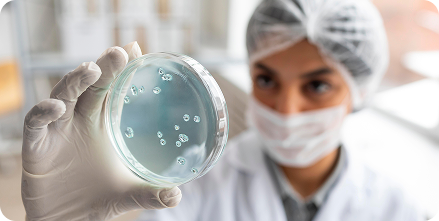
Treatment

India’s first Advanced Fertility, Oncology Day Care & Transition Care Center. All Under One Roof!
- Every 7th Couple in India faces fertility Issues and treatment is easy
- For 40% of cancers you don’t need to visit Cancer Hospitals, queue up with stage 4 cancer people, treatment is available with better results
- You don’t need to spend too much despite of best treatments in hassle free environment
We at VIOC , provide compassionate evidence based fertility, Oncology & transition care using personalised treatment protocols & best medical technology